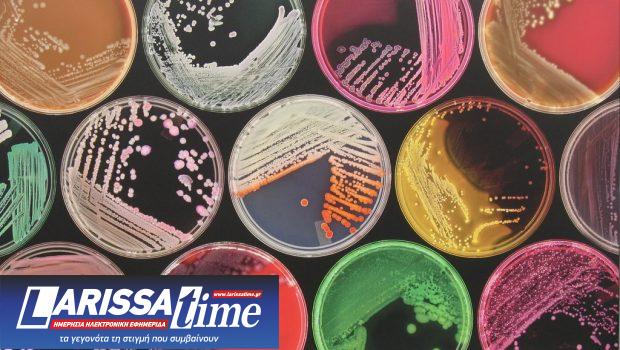
petri-dishes-620x350.jpg

Επικίνδυνα υψηλή παραμένει σήμερα η μικροβιακή αντοχή σε ορισμένες χώρες όπως η Ελλάδα.
Η χώρα μας κατατάσσεται πρώτη μεταξύ των ευρωπαϊκών χωρών από πλευράς ενδονοσοκομειακών λοιμώξεων, ενώ καταγράφει ένα από τα υψηλότερα ποσοστά μικροβιακής αντοχής στην Ευρώπη για συγκεκριμένα μικροβιακά στελέχη.
Επιπλέον, πρόσφατη έκθεση του ECDC απέδωσε στην Ελλάδα την αρνητική πρωτιά σε ότι αφορά τα περισσότερα έτη ζωής που χάνονται λόγω μικροβιακής αντοχής.
Στις χώρες με υψηλή μικροβιακή ανοχή, περισσότερο από το 40% των λοιμώξεων που προκαλούνται από τους 12 συνδυασμούς αντιβιοτικών-υπερμικροβίων που μελέτησε ο ΟΟΣΑ, αναμένεται να είναι ανθεκτικοί στα αντιβιοτικά έως το 2035.
Το κόστος της αδράνειας για την αντιμετώπιση της μικροβιακής αντοχής είναι υψηλό.
Το κόστος της θεραπείας των επιπλοκών λόγω ανθεκτικών λοιμώξεων σε 34 χώρες του ΟΟΣΑ και της ΕΕ/ΕΟΧ, μπορεί να ξεπερνά τα 28,9 δις δολ. κάθε χρόνο.
Τα παραπάνω στοιχεία παρέθεσε ο Καθηγητής Οικονομικών Υγείας και Διευθυντής ΜΒΑ HEALTH ECONOMICS του ΕΚΠΑ Γιάννης Υφαντόπουλος σε ομιλία του με θέμα «Η οικονομική διαχείριση των Ενδονοσοκομειακών Λοιμώξεων», στο πλαίσιο του συνεδρίου της Πανελλήνιας Ένωσης Φαρμακοποιών Νοσηλευτικών Ιδρυμάτων (ΠΕΦΝΙ).

Ο καθηγητής Οικονομικών της Υγείας και διευθυντής του MBA Health Economics του ΕΚΠΑ Γιάννης Υφαντόπουλος
Η ανθρώπινη κατανάλωση αντιβιοτικών σε όλο τον κόσμο έχει αυξηθεί κατά σχεδόν 40% σε μια δεκαετία – μεταξύ 2000 και 2010
Στην Ελλάδα
Ο κ. Υφαντόπουλος αναφέρθηκε σε μελέτη του ΕΟΔΥ σε 50 νοσοκομεία, σύμφωνα με την οποία, οι νοσοκομειακές λοιμώξεις και η μικροβιακή αντοχή αποτελούν απειλή για τους ασθενείς, καθώς σχετίζονται με αυξημένη νοσηρότητα, θνητότητα και διάρκεια νοσηλείας.
Σε μελέτη καταγραφής του επιπολασμού των λοιμώξεων που συνδέονται με χώρους παροχής υγείας και της χρήσης αντιβιοτικών το διάστημα 2022-2023 ο επιπολασμός ανήλθε σε 12,1%, ενώ έξι χρόνια νωρίτερα, σε αντίστοιχη μελέτη το 2016-2017 ήταν 10%.
Η κατανάλωση αντιβιοτικών το 2022-2023 κυμάνθηκε σε παρόμοια επίπεδα με το 2016-2017 (στο 55,4%) ήταν όμως, σημαντικά μεγαλύτερος από τον αντίστοιχο ευρωπαϊκό μέσο όρο.
Επιπλέον όμως, επιβαρύνουν οικονομικά σε μεγάλο βαθμό τόσο το σύστημα υγείας, τον ΕΟΠΥΥ, καθώς και τις ασφαλιστικές εταιρείες, όσο και τους ίδιους τους ασθενείς.
Αυξημένο κόστος περίθαλψης
Για σύγκριση, ανέφερε ότι σε 17 χώρες όπου υπάρχουν διαθέσιμα δεδομένα, οι συνολικές δαπάνες υγείας που πραγματοποιούνται κάθε χρόνο λόγω της μικροβιακή αντοχής είναι περίπου το 19% των συνολικών δαπανών για την υγεία.
Επίσης αναφέρθηκε σε μελέτη που αφορούσε λοιμώξεις μετά από λαπαροσκόπηση, στο σημείο της επέμβασης, οι οποίες παρατηρούνται στο 25% των ασθενών. Σύμφωνα με την μελέτη αυτή, η νοσοκομειακή περίθαλψη είναι σημαντικά αυξημένη εφόσον υπάρχει τοπική λοίμωξη στο σημείο της επέμβασης, στα 16.685 ευρώ, έναντι 11.235 ευρώ σε ασθενείς χωρίς λοίμωξη.
Αντίστοιχα αυξημένο είναι και το μέσο χειρουργικό κόστος, στα 6.664 ευρώ έναντι 5.040 ευρώ σε ασθενείς χωρίς λοίμωξη, ενώ το μέσο κόστος της χειρουργικής κλινικής ανεβαίνει στα 8.404 ευρώ στους ασθενείς με λοίμωξη, από 4.690 ευρώ χωρίς λοίμωξη.
Αναφέρθηκε επίσης σε ανασκόπηση από 29 μελέτες, το 69% των οποίων αφορούσε οικονομίες υψηλού εισοδήματος. Οι 26 από τις 29 μελέτες αφορούσαν μονάδες υγείας πρωτοβάθμιας περίθαλψης και νοσοκομεία, ενώ οι 13 από τις 29 αφορούσαν νοσοκομεία τριτοβάθμιας περίθαλψης.
Το κόστος που αποδόθηκε στις ανθεκτικές λοιμώξεις κυμάνθηκε μεταξύ 2.371-29.289 δολ ανά ασθενή (προσαρμοσμένο σε τιμές 2020), ενώ η μέση πρόσθετη διάρκεια παραμονής στο νοσοκομείο ήταν 7,4 ημέρες.

Η κατανάλωση αντιβιοτικών ανά χώρα
Πόσα αντιβιοτικά καταναλώνουμε;
Η κατανάλωση ειδικών αντιβιοτικών που χρησιμοποιούνται για τη θεραπεία πολυανθεκτικών βακτηριακών λοιμώξεων έχει σχεδόν διπλασιαστεί στην Ευρώπη μεταξύ 2010-2014.
Τα καλά νέα είναι ότι σημειώθηκε σημαντική μείωση στην κατανάλωση αντιβιοτικών στην κοινότητα (εκτός νοσοκομείων) σε 6 χώρες (Δανία, Εσθονία, Φινλανδία, Λουξεμβούργο, Ισπανία, Σουηδία).
Όμως σε ότι αφορά την κατανάλωση αντιβιοτικών στα ζώα, μπορεί να μειώθηκε συνολικά κατά 12% σε 24 χώρες της ΕΕ τα έτη 2011 – 2014, όμως μεταξύ των χωρών, οι διαφορές είναι μεγάλες και κυμαίνονται από μείωση σε 9 χώρες μέχρι την αύξηση χρήσης αντιβιοτικών στα ζώα σε πέντε χώρες.
Αντίσταση – φυσικό φαινόμενο
Όπως τόνισε ο καθηγητής, αν και η αντίσταση στα αντιβιοτικά είναι φυσικό φαινόμενο, η διαδικασία της αντίστασης επιταχύνεται από την υπερβολική χρήση και την κακή χρήση αντιβιοτικών και τα διηπειρωτικά ταξίδια. Στο παρελθόν, οι ανθεκτικές λοιμώξεις συνδέονταν με νοσοκομεία και χώρους φροντίδας, όμως τις τελευταίες δεκαετίες έχουν εξαπλωθεί στην ευρύτερη κοινότητα.
Επιπλέον, η ανθρώπινη κατανάλωση αντιβιοτικών σε όλο τον κόσμο έχει αυξηθεί κατά σχεδόν 40% σε μια δεκαετία – μεταξύ 2000 και 2010.
Τα στοιχεία δείχνουν ότι οι χώρες χαμηλού και μεσαίου εισοδήματος εξακολουθούν να είναι πολύ πίσω από τις χώρες υψηλού εισοδήματος όσον αφορά την καταστολή της εξάπλωσης της αντίστασης στα αντιβιοτικά.
Το οικονομικό κόστος της αντίστασης
Σύμφωνα με τον καθηγητή, το κόστος της μικροβιακής αντίστασης εκτιμάται σε:
- 1,5 δις. ευρώ κάθε χρόνο – Επιπλέον κόστος υγειονομικής περίθαλψης και απώλειες παραγωγικότητας λόγω πολυανθεκτικών βακτηρίων στην ΕΕ.
- 2,9 τρις. δολ. ως το 2050 – Αναμενόμενες σωρευτικές απώλειες στις χώρες του ΟΟΣΑ
- 000 έως 40.000 δολ – Πρόσθετες νοσοκομειακές δαπάνες ανά ασθενή στις χώρες του ΟΟΣΑ.
- Ο σχετικός αντίκτυπος των χαμένων οικονομικών εκροών λόγω της αυξημένης θνησιμότητας, της παρατεταμένης ασθένειας και της μειωμένης αποδοτικότητας της εργασίας είναι πιθανό να διπλασιάσει αυτό το ποσό.
- Απώλειες στο εμπόριο και τη γεωργία – Για παράδειγμα, το 2015 οι πωλήσεις κοτόπουλου στη Νορβηγία μειώθηκαν κατά 20% (για ορισμένους διανομείς) μετά την είδηση ότι ένα ανθεκτικό στέλεχος Escherichia coli βρέθηκε στο κρέας κοτόπουλου.

Μεγαλύτερες είναι οι ποσότητες αντιβιοτικών που χορηγούνται στην κτηνοτροφία, έναντι αυτών που χορηγούνται στους ανθρώπους
Επιπτώσεις στο ΑΕΠ
Αντίστοιχα, σε ότι αφορά τις επιπτώσεις στο ΑΕΠ, ο καθηγητής ανέφερε ότι:
- Η μικροβιακή αντίσταση μπορεί να οδηγήσει σε μείωση του ακαθάριστου εγχώριου προϊόντος (ΑΕΠ) κατά 1,1%.
- Μπορεί να υπερβεί το 1 τρις. δολ. ετησίως μετά το 2030 σε ολόκληρο τον κόσμο, σε ένα σενάριο χαμηλού αντίκτυπου.
- Σε χώρες της G20, όπως η Ρωσική Ομοσπονδία, η Κίνα και η Ινδία, πάνω από το 40% των λοιμώξεων προκλήθηκαν από ανθεκτικά βακτήρια και περίπου το 17% στις χώρες του ΟΟΣΑ .
- Επιπλέον, η χρήση αντιβιοτικών στη γεωργία, ιδιαίτερα στην κτηνοτροφία, είναι σημαντική σε όλο τον κόσμο.
- Μόνο το 2010, υπολογίζεται ότι χρησιμοποιήθηκαν 200 τόνοι αντιβιοτικών στα ζώα σε όλο τον κόσμο, πιθανώς πολύ περισσότερο από τη συνολική ανθρώπινη κατανάλωση.
- Μόνο στις ΗΠΑ, πάνω από το 70% των αντιβιοτικών πωλούνται για κτηνοτροφική χρήση σε σύγκριση με τον άνθρωπο.
- Ωστόσο, πολλές χώρες δεν διαθέτουν πληροφορίες για τη χρήση αντιβιοτικών στη γεωργία και οι λεπτομερείς επιπτώσεις της χρήσης αντιβιοτικών στη γεωργία, το περιβάλλον, την ανθρώπινη υγεία και την οικονομία είναι σπάνιες.